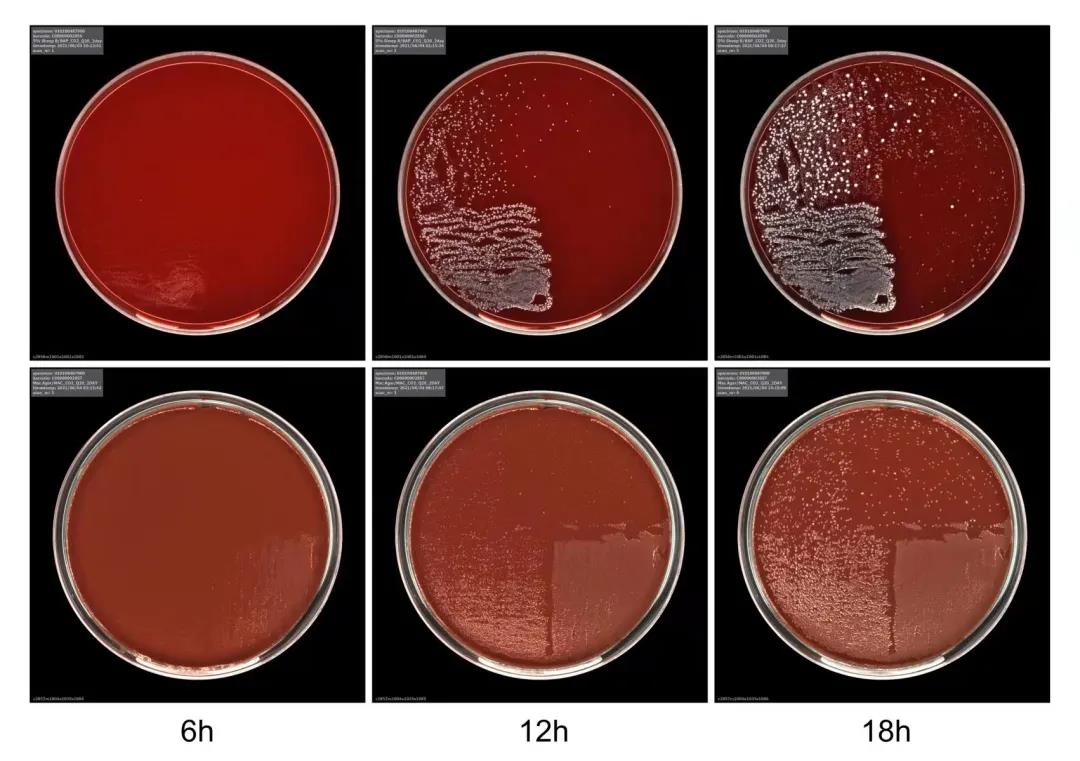
1638868636129065.jpg

在每年各类检验年会和论坛上,日渐火爆的一个主题就是检验医学的自动化和智能化发展。临检、生化和免疫等检验的自动化操作已经广泛普及,一些前瞻性的研究团队正在研究人工智能来进行智能报告审核和疾病诊断。而同为检验科的临床微生物实验室,自动化和智能化的发展相对缓慢,手工操作多、实验步骤繁琐和TAT时间长等仿佛成为了微生物检验的标签,与临检、生化和免疫的规模化流水线相比,微生物检验在自动化和智能化的道路上任重道远。

制约微生物自动化和智能化发展包括很多因素,主要是微生物标本类型的复杂性、病原体的多样性、操作的繁琐性以及传统习惯的束缚等。但微生物自动化和智能化发展非常有必要,自动化不仅可保证同质化操作和提高检验质量、缩短TAT,更可以解放微生物检验人员的双手,把更多精力投入到报告解读和与临床沟通中,帮助临床实现病原学的精准诊治。

基于以上背景,西安区域医学检验中心临床微生物检测部尝试突破这种传统的局限和束缚,探索了我们的自动化和智能化微生物实验室模式。这种模式主要有三个方面:以Kiestra+Epicenter为核心的全自动解决方案;助力精准诊断的多重病原体快速检测平台;实验室控制的全局智能化和信息化。

西安区域医学检验中心
临床微生物检测部
以Kiestra+Epicenter为核心的全自动解决方案
临床微生物检测部引进了亚太地区最大的BD Kiestra全自动微生物流水线,实现了自动接种→智能培养→智能阅板的整个培养过程的自动化和智能化。通过自动化接种实现画线的同质化,并可以通过整个软件系统动态阅板,减少人为操作环节,数字化记录和监控培养过程。
Kiestra自动化和智能化的培养过程
Kiestra是对于整个培养过程的自动化和智能化操作,而在Kiestra培养任务完成后,是以Epicenter为核心的自动化解决方案。Epicenter是整合了血培养、结核培养、质谱鉴定和全自动药敏的微生物数据管理系统,血培养和结核液体培养报阳性的TTD时间和曲线结果均可以在Epicenter查看,并实现阶段性的数据统计;而质谱鉴定和全自动药敏的结果传输到Epicenter实现鉴定和药敏结果的整合,根据专家规则得出个性化的药敏结果。数据的整合加强了实验过程的把控,并提高了效率,减少了TAT时间中的浪费和冗余。

以Kiestra+Epicenter为核心的
全自动解决方案
助力精准诊断的多重病原体快速检测平台
分子生物学技术飞速的发展对于微生物的检验也是强有力的手段,西安医检微生物引进了博奥13种下呼吸道医院感染病原体检测平台、GeneXpert全自动病原体检测系统、Luminex全自动多重病原体芯片检测系统、BD MAX全自动核酸提取及PCR扩增分析系统、病原微生物高通量测序(mNGS)等多种分子生物学的检测平台,可以实现对病毒和少见病原体感染及疑难危重不明病原体感染的快速精准诊断。

多重病原体快速检测平台
实验室控制的全局智能化和信息化
检验质量的控制不仅仅是实验过程的质量控制,实验室的环境和各类仪器设备的状态监测控制也是检验结果和质量的保证。例如二氧化碳培养箱和冰箱的日常状态监控等,实现了手机和电脑终端的实时监测,及时预警异常情况的发生。此外,以Kiestra+Epicenter为核心的全自动化解决方案也实现了日常仪器状态和标本量等监控,及时提示实验室各类标本的状态。这些信息化和智能化的控制系统更加方便了实验室对整体工作流程的优化和仪器状态的监控,实现了对检验环节的全局把控,提高实验室效率和检验质量,更精准地发出报告。

实验室冰箱/培养箱/环境温湿度冷链控制

实验室流水线监控大屏
自动化和智能化是检验医学发展的必然趋势,人工智能会进一步促进检验医学革命性,临床微生物实验室在这一方面的发展因微生物学科的特殊性相对缓慢。西安区域医学检验中心临床微生物部根据临床微生物学科的发展要求和未来方向,在自动化和智能化的道路上迈出了探索性步伐,但自动化和智能化的内涵还远不止这些,随着实践工作的深入和新技术的发展,我们做为一个开放性的平台,将继续探索新的可能,持续提升实验室质量和效率,不断满足临床需求,助力实现感染性疾病的快速、精准诊断和治疗。